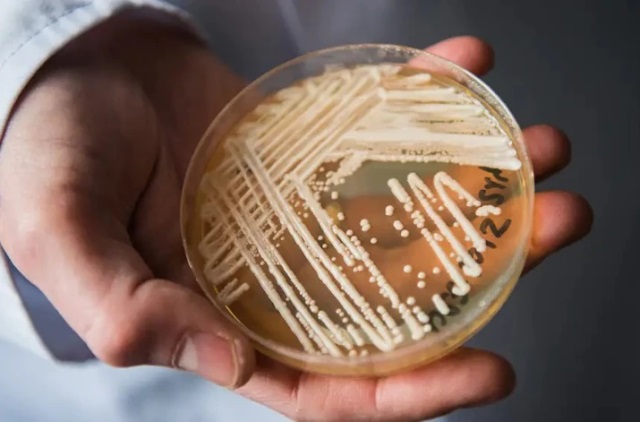

RN lidera dívidas no Nordeste: 49,6% dos potiguares no sufoco, diz Serasa
O RN fechou 2025 com 49,65% da população adulta com alguma dívida em atraso. São cerca de 1,24 milhão de potiguares endividados, 100 mil a mais que em 2024, segundo o Mapa da Inadimplência do Brasil, da Serasa. O ritmo de crescimento supera a média nacional e coloca o estado como destaque negativo na região […]
RN lidera dívidas no Nordeste: 49,6% dos potiguares no sufoco, diz Serasa Read More »